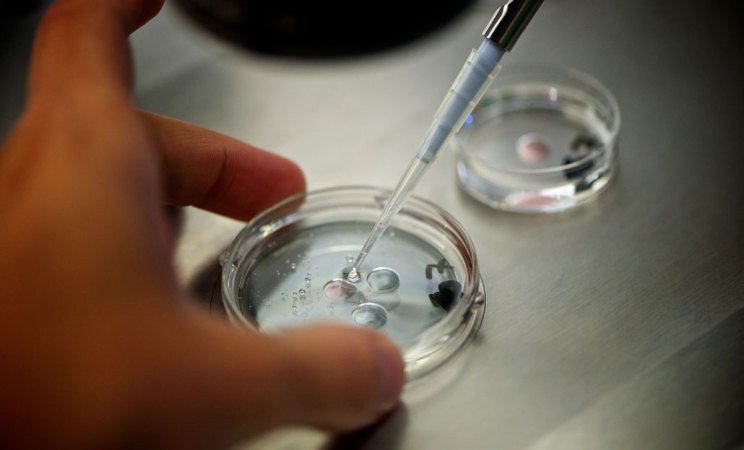
a pipette in a petrii dish held by a hand

JGI/Jamie Grill/Getty Images
Where babies come from
In the beginning, no one really understood how babies were made. Thinkers puzzled for millennia about how life arose from one generation to the next, but not until the 17th century did scientists start to seriously study the question. At that time, they generally settled on some variation of the theory of preformation, which states that minuscule humans already existed, fully formed, in either the mother’s menstrual blood or the father’s semen, depending on whether you were an “ovist” or a “spermist.”
And there the thinking remained for another couple hundred years, until two late-19th century scientists, Oskar Hertwig from Germany and Hermann Fol from France, independently conducted experiments on sea urchins proving conclusively that it took both one egg and one sperm to create new offspring.

Despite the early confusion, the ancients were sure about one thing: Reproduction is far from a sure bet. Today, an estimated 15 percent of couples worldwide are unable to conceive a child naturally, leading to feelings of sorrow, loss and a profound sense of inadequacy for many. A century ago, science didn’t have much to offer these “barren” couples. The only fertility intervention widely available in 1921 was artificial insemination by donor, which was morally and legally fraught. In the first half of the 20th century, the practice was often considered a form of adultery; as recently as 1963, an Illinois court ruled that a baby conceived this way, even with the husband’s consent, was illegitimate.
But after 1978, everything changed. The birth of Louise Brown, the world’s first “test tube baby,” proved there was another option for infertile couples — in vitro fertilization. The technique involved removing a mature egg from the mother, mixing it in a lab dish with the father’s sperm, and letting the fertilized egg, called a zygote, grow for a couple of days. The zygote was then returned to the mother’s uterus, where it could implant and grow in an otherwise normal pregnancy.
Since Brown’s historic birth, scientists now have a range of ways to give Mother Nature a boost in baby-making. The various methods are known collectively as assisted reproductive technology, or ART, an acronym that subtly invokes the artistry of this branch of science. Among the beneficiaries of this ever-evolving field of investigation have been the families of some 9 million babies born worldwide using versions of ART.
The impact has been as profound sociologically as it has been medically. Now that ART has become almost routine, many of the early complaints about scientists playing God and manipulating life have faded away. Now parenthood is possible for people who never imagined it in their futures, including same-sex couples and single parents, thanks to such refinements as egg donors, surrogacy and the successful freezing of eggs, sperm and embryos. In the 21st century, people have more power than ever thought possible in setting their own timetables for procreation. And all of it begins, as human life itself does, with the egg.
— Robin Marantz Henig
Good eggs

Even scientists can’t make babies without eggs. They’re a precious resource because, in the normal scheme of things, a woman produces only one mature egg every month, and their quality tends to decline by her late 30s. So researchers’ ability to retrieve and prepare this scarce resource for fertilization, and if necessary preserve the eggs through freezing, have all been crucial in assisting reproduction.
Women have two ovaries, each one containing thousands of immature egg follicles. During the childbearing years, the ovaries usually release mature eggs in rotation: a single mature egg bursting from the right-hand ovary one menstrual cycle, from the left-hand ovary the next.
But women using ART often rely on injections of various fertility hormones to get the process going. These shots will enable sluggish ovaries to produce eggs that can be fertilized either through intercourse or in the lab via IVF. For IVF, the most robust-looking candidates are chosen to implant or to freeze for later use. This first step in assisted reproductive technology, or ART, it turns out, is also one of the trickiest: choosing the right hormones to get the eggs you need.
Knowledge about hormones and how they affect ovulation dates back to 1923, when two scientists at Washington University School of Medicine in St. Louis, Edgar Allen and Edward Doisy, first isolated estrogen in experimental mice and rats and found that it was produced in the ovaries. By the 1940s, scientists had elucidated the ebbs and flows of other hormones in lab animals and humans — follicle stimulating hormone, luteinizing hormone and human chorionic gonadotropin — over the course of a typical menstrual cycle.
ART usually begins with a woman giving herself daily injections containing a cocktail of these hormones, generally for 10 to 14 days. But for some women with cancer, hormone injections aren’t an option — and the clock is ticking. They need to start cancer treatments as soon as possible, but many of the treatments are likely to damage the reproductive system. To preserve their fertility, these women might choose to freeze their eggs before they start treatment. But they might not have 10 or so days to wait until the hormone injections provoke their ovaries to produce extra eggs — nor might they be able to take the drugs in the first place if they have a hormone-sensitive cancer, such as some breast cancers, that ovulation-stimulating drugs might make worse. So for these women, researchers had to find ways to bring a bunch of eggs to maturity all at once and outside the body — a technique known as in vitro maturation.
In vitro maturation was first used in 1934, when Harvard researchers Gregory Pincus and E.V. Enzmann used it in rabbits. The two scientists cultured immature rabbit eggs for about a day, supplementing the nutrient broth either with extracts from cow pituitary glands or with an unspecified “maturity hormone.” Both supplements helped the immature eggs grow to maturity, at which point they were successfully fertilized.


In 1940, Pincus was asked by a New York Times reporter what the next big development might be in reproductive science. “There are no big steps, there are all little steps,” he said, declining to make any predictions. All he knew for sure, he said, was that the “big questions” of the day were why an egg starts to develop and why it continues to develop.
When reproductive endocrinologists retrieve eggs from their ART patients, after either stimulating the ovaries via hormone injections or maturing the eggs in the lab, they have two choices: fertilize the eggs and implant the embryo right away, or store them. For women who are not yet ready to have a baby, storing the eggs is the best option. This is done through freezing — which, in the early days of ART, was a tricky business indeed. Eggs have a high fluid content that leads them to form crystals when frozen; during thawing, those crystals can damage the egg, especially the delicate apparatus needed to cut the cell’s chromosome number in half. By dividing the chromosomes, one egg plus one sperm can fuse together without doubling the chromosome count.
In the 1980s, egg freezing worked occasionally; the first successful pregnancy using a woman’s own frozen eggs, leading to the birth of healthy twins, was reported in 1986 by Christopher Chen of Flinders University of South Australia in Adelaide. But egg freezing was still a long shot. Estimates were that no more than 1 or 2 percent of thawed eggs would result in a live birth.
Then, in 1999, reports appeared of a more reliable freezing method: vitrification, which freezes the egg so rapidly that no ice crystals can form. A research team based in Australia and Italy described animal experiments in which 1 in 4 vitrified cow eggs were fertilized and later grew, by around day 5, to the blastocyst stage. It was only about half the rate achieved for fresh cow eggs, but it was still several times better than the rate for slow-frozen eggs. When it came to clinical use, some researchers put the live birth rate of vitrified eggs at about 2 to 12 percent for women under age 38.

At first, vitrification was limited to people who froze their eggs for medical reasons such as cancer. But in 2013, egg cryopreservation became an option for anyone who wanted to delay childbearing for any reason, medical or not.
By 2020, estimates were that a growing subset of women who choose egg vitrification each year in the United States do so because they’re not ready to have children yet but hope to eventually — lifestyle-related reasons that have come to be known as “social freezing.”
While social freezing is often promoted as a way to delay childbearing almost indefinitely, it turns out that most women never even return to the clinic to use their frozen eggs. At McGill University in Montreal, for instance, William Buckett and his colleagues found that over the course of 13 years, the school’s cancer fertility preservation program treated 353 women, of whom 9 percent died, 6 percent got pregnant spontaneously, and the majority were either still dealing with their cancer or had lost touch with the clinic for unknown reasons. Just 23 women, 6.5 percent of the group, came back to McGill to use their frozen eggs or embryos. (Embryos are easier to freeze than eggs, but women without partners often choose to freeze just the eggs rather than create embryos with sperm from an anonymous donor.) That low rate is also true of egg-freezing programs that involve women who opt for social freezing.
— Robin Marantz Henig
Spotlight
What 20th century science fiction got right and wrong about the future of babies
A century of science has pushed the boundaries of human reproduction even beyond writers’ imaginations.
Sperm meets egg

Figuring out sperm should be the easy part of understanding reproduction. Compared with the human egg, sperm are pretty simple. They were first observed in 1677 when Antonie van Leeuwenhoek, the Dutch inventor of one of the world’s first microscopes, took a look at his own ejaculate under magnification and noticed what he called “animalcules” swimming around in the sample. But their structure and function didn’t come into focus until 1876, when the German zoologist Oskar Hertwig watched a sperm fertilize the egg of a sea urchin.
Gregory Pincus and E.V. Enzmann of Harvard, who were the first to bring mammalian eggs to maturity in the lab, used rabbit sperm to achieve the first laboratory fertilization in a mammal in 1934. They mixed sperm from rabbits with one coat color with eggs from rabbits with a different coat color in a lab dish, observed “the events ordinarily occurring during insemination,” and transferred the resulting fertilized egg, or zygote, into the uterus of a rabbit with a third coat color (the different colors were chosen so the lineage of the resulting rabbits would be apparent). With that experiment, Pincus and Enzmann created the world’s first “test tube baby” mammals: two litters of baby rabbits, nine in all, born to two different surrogate mothers after in vitro fertilization, or IVF.
But scientists then struggled for years to fertilize human eggs in the lab, and weren’t sure if they would ever be able to make the leap from rabbits to humans. In 1951, an oddity of sperm made it seem that Pincus and Enzmann had gotten lucky. Sperm cells, it appeared, needed to be primed in some way through a process called capacitation before they could pierce the egg.
Robert Edwards of Cambridge University was one of the world’s leading investigators in IVF through the 1960s and 1970s, and he thought capacitation would be “a terrible obstacle to IVF,” recalls Roger Gosden, an embryologist who worked in Edwards’ lab and authored Edwards’ biography, Let There Be Life. He remembers some frantic attempts to mimic sperm capacitation — such as when scientists created porous chambers, roughly the size of an implanted IUD, or intrauterine device, used for contraception. The researchers would fill a chamber with sperm and insert it into the uterus of a volunteer, hoping to expose the sperm to whatever unknown capacitating substance exists in nature. After waiting a bit, the scientists would pull on a string attached to the chamber to retrieve the now “primed” sperm to see if they had indeed become better able to fertilize eggs in the lab.
In the end, scientists found they hadn’t really needed to worry about artificial sperm capacitation for human reproduction. “You just have to wash the sperm to get rid of some surface constituents,” Gosden says, and the sperm are ready to fertilize an egg in a lab dish. Other difficulties in clinical research proved more formidable, such as gauging the best timing of egg retrieval from women, and tweaking how many days post-fertilization were best to transfer the zygote to the uterus. Edwards and his collaborators, including gynecologist Patrick Steptoe, had more than 300 failed attempts at in vitro fertilization before their first success with Louise Brown in 1978 in England. Edwards went on to win the Nobel Prize in 2010 for his IVF discoveries.

Among the beneficiaries of Edwards’ pathbreaking work is Claudy, a young French woman who was diagnosed with breast cancer at the age of 29, and who in a different century might never have been able to have a baby of her own. Claudy sought out Michaël Grynberg and his colleagues at the Antoine Béclère University Hospital fertility clinic, just outside Paris, to discuss ways to preserve her fertility. It was 2014, when egg freezing through vitrification was becoming more common, but bringing an immature egg to maturity in the lab was still relatively rare. From the time of the first baby born from fresh lab-matured eggs in 1991 to the time of Claudy’s arrival at Grynberg’s clinic, only about 5,000 such births had occurred, a number dwarfed by the millions of babies born involving all of assisted reproductive technology, or ART.
But Grynberg had no choice. He had to retrieve immature eggs from Claudy, for the sake of both speed and to avoid aggravating her hormone-sensitive breast cancer with fertility drugs. In addition, he would have to do something unprecedented in the context of cancer: Freeze those lab-matured eggs for later use. No baby had ever been born from eggs taken from a cancer patient that were matured in the lab and then frozen. If it worked for Claudy, it would be the first such birth on record in the context of cancer. (There had been one baby born at McGill in 2009 from a woman who did not have cancer, whose eggs were matured in the lab and frozen, then thawed.)
Grynberg extracted seven immature eggs and was able to grow six of them to maturity over the next 48 hours. He vitrified all six and kept them in the deep freeze, while Claudy had breast cancer surgery and chemotherapy.
A few years later, Claudy’s oncologist told her it was safe for her to get pregnant, and she spent a year trying to conceive. But she didn’t, and in 2018 she returned to Grynberg’s clinic, where the doctors prepared to thaw her six frozen eggs.
To fertilize them, in Claudy’s case, required an additional bit of ART. Because her eggs had been frozen, her partner’s sperm wouldn’t be able to fertilize her eggs without help. Vitrification causes changes in the egg’s outer membrane that makes the thawed egg particularly hard for sperm cells to penetrate. This membrane, called the zona pellucida, is a formidable barrier even in nature. One of the first to describe it was Sardul Singh Guraya, a biologist at Punjab Agricultural University in India, who did his early work in field rats. The zona pellucida, Guraya reported in 1978, is a barrier around the egg made of proteins and carbohydrates, and when one sperm breaches it, cortical granules rearrange themselves to shut out all other sperm. This makes it virtually impossible for more than one sperm to penetrate, ensuring that the zygote will have a normal genetic complement of just two pairs of 23 chromosomes, one from the mother and one from the father, rather than a grossly inflated number that would result if multiple sperm fertilized the egg.

Scientists spent much of the next decade trying to get sperm into eggs that had been frozen using micro-manipulations described with such invasive terms as “zona drilling.” In the late 1980s, researchers tried a gentler approach, using a needle to insert a single sperm just under the outer layer. But the sperm still failed to reach the nucleus for fertilization.
Then in 1992, Gianpiero Palermo, an Italian scientist on sabbatical from the University of Bari, reported on an accidental discovery he made while working in the fertility lab at the Free University of Brussels. When he tried to gently insert sperm beneath the outer layer of the egg, careful not to pierce the jellylike center known as the cytoplasm, he noticed that an occasional “dimple” in the membrane would allow the sperm to penetrate directly into the center anyway. When that happened, the egg was almost always fertilized. So despite the general recommendation to avoid doing so, Palermo tried injecting the sperm, tail and all, directly into the cytoplasm.
Of the first 47 attempts Palermo and his colleagues in Brussels made with this approach, 38 eggs remained intact after the injection, 31 were fertilized and 15 grew to embryos that could be transferred to a uterus.

Ultimately, four babies were born: two healthy boys from two singleton pregnancies, and a healthy pair of boy-and-girl twins. They were the first four babies born from this procedure, which the Belgian scientists called ICSI (pronounced ICK-see), shorthand for intracytoplasmic sperm injection.
ICSI was originally developed to treat male-factor infertility — that is, problems conceiving that can be traced to some trouble with the sperm. Directly injecting a single sperm into a single egg is a crucial boost for sperm that lack the swimming power, shape, or other characteristics to fertilize eggs on their own. Today, injecting a single sperm directly into an egg is even more common than the traditional form of IVF, which involves just adding sperm to an egg in a lab dish and letting fertilization happen on its own. The injection method is used in about two-thirds of ART cycles around the world, and it is used in virtually all cycles that, like Claudy’s, start out with a hard-shelled frozen egg.
— Robin Marantz Henig
Early days of life

When Claudy returns to the fertility clinic at the Antoine Béclère University Hospital in suburban Paris, she is 34 years old, cancer-free, and ready to use the eggs she froze five years earlier. Because of the unusual nature of her case — her eggs were immature when they were retrieved and were brought to maturity in the laboratory — her doctors are not confident the eggs will survive the thawing and subsequent manipulations. No lab-matured eggs have ever been frozen, thawed, successfully fertilized, transferred to a uterus and grown into a healthy baby.
All six of Claudy’s eggs defrost with no apparent damage. The scientists perform ICSI, or intracytoplasmic sperm injection, using fresh sperm from Claudy’s partner. Five of the eggs fertilize.
These five zygotes go into an incubator so they can develop to a stage that is ready to implant. They undergo the early stages of cleavage, in which one cell becomes two, two become four, four become eight, and so on.

At many fertility clinics elsewhere in the world, doctors might interrupt things at this point so they can snip off a cell or two from the early embryo to see if things are progressing normally. It was revolutionary to discover that this could even be done – a feat first accomplished in 1968 by embryologist Richard Gardner. At the time, Gardner was a graduate student working in the Cambridge lab of Robert Edwards. His work showed for the first time that it was possible in rabbits to take cells from a blastocyst without causing harm.
When scientists examine the chromosomes of a few cells in a human embryo, they might be looking for a particular disease-linked gene that runs in the family, to avoid implanting an affected embryo in the uterus. Or they might be hoping to reassure themselves that a developing embryo has the right number of chromosomes, that all the chromosomes look good, and that the embryo has a good chance of implanting in the uterus, developing normally and coming out a baby with 10 fingers, 10 toes and the chance of a healthy life.
This snip-and-see procedure, known as preimplantation genetic diagnosis, has its roots in work on pre-natal sex determination reported in 1956. One of these studies was conducted by T.W. Glenister, an anatomy professor at the Charing Cross Hospital Medical School in London, who examined some early embryos in the hospital’s specimen collection to see if he could tell whether they were destined to be boys or girls. He stained the cells, and those that contained a compound known as sex chromatin in the nucleus picked up the stain, Glenister wrote, and could be identified as female. Those without sex chromatin in the cell nucleus were male — a prediction he confirmed by examining that embryo’s reproductive tract.
A generation later, in 1989, Alan Handyside and his colleagues at London’s Hammersmith Hospital, along with collaborators at University College, London, conducted further pre-clinical research on the procedure using 30 “surplus” embryos from in vitro fertilization that were at the very early cleavage stage (6 to 10 cells). In each embryo they snipped out one cell to look for a Y chromosome, which would indicate the embryo would grow to be a male. After the procedure, the embryos were allowed to grow in the lab for a few more days. About 37 percent went on to develop normally to the blastocyst stage — about the same rate, wrote Handyside and his colleagues, that was seen at reproductive clinics at the time.
Nonetheless, the researchers urged caution in applying the technique widely in a clinical setting. As far as they could tell, the blastocysts that had been interfered with at the cleavage stage looked likely to develop into normal embryos, but that was based mostly on a visual assessment of the blastocyst’s overall shape and structure, or what the experts call “good morphological development.” That meant that under a microscope, the outer cells of the blastocyst, which would eventually become the placenta, seemed symmetrical and evenly spaced, and the cells in the interior, which would become the fetus, appeared to be tightly packed. Handyside and his colleagues pointed out that this organized appearance was a good sign, but it did not necessarily guarantee that the blastocyst would implant in the uterus and develop into a healthy baby.
But that was what everyone wanted to know: Would the lab-fertilized blastocyst implant in the uterus, and if it did, would it be normal? Today, they might also want to know whether a particular disease gene that ran in the family was or wasn’t present. In the future, they might also want to know whether a desired gene tweak, introduced via a gene-editing technique like CRISPR, had actually taken hold. Without PGD, none of these approaches, from disease prevention to designer babies, could take place.
That question — whether “normal” shape and “normal” chromosomes predict a healthy outcome — continues to bedevil those working with preimplantation genetic diagnosis, which is now offered in an estimated three-quarters of all fertility clinics in the United States.
— Robin Marantz Henig
Growing a baby

In 2018, Claudy returns to the fertility clinic at the Antoine Béclère University Hospital in suburban Paris to claim and thaw the lab-matured eggs she had saved before her breast cancer treatment. She is 34 years old and cancer-free. Because of the unusual nature of her case — her eggs were immature when they were retrieved and were brought to maturity in the laboratory — her doctors are not confident the eggs will survive the thawing and subsequent manipulations.
But luckily, doctors are able to fertilize five of her eggs with her partner’s sperm by individually injecting one sperm cell into each egg. The embryos are placed in an incubator so they can keep growing. The doctors do not plan to use preimplantation genetic diagnosis, which is strictly regulated in France. But no matter; fate does not give them a choice anyway about which embryo is “best.” Two days after putting Claudy’s five embryos in the incubator, only one is still undergoing cleavage. That is the embryo the doctors transfer to Claudy’s uterus.

The embryo implants, and continues to develop the way any embryo would, no matter what its origin story — a ball of a few hundred genetically identical embryonic cells that eventually differentiate into the 200 or so cell types that make up a human being. The mechanism by which this occurs was first laid out in 1924 by the German investigator Hans Spemann, who discovered the “organizer effect” that leads particular regions of the embryo to develop into particular cell types. In one of a series of experiments, Spemann transplanted tissue from one newt embryo to another, which resulted in an embryo with a second nervous system. Such findings led Spemann to describe that patch of tissue as an “organizer,” and to develop the theory that embryonic cells differentiate partly in response to changes in neighboring cells.
In 1965, Beatrice Mintz created mice that wore their bizarre genetic lineage on their unique, black-and-white striped coats. In her lab at the Institute for Cancer Research in Philadelphia, she created a mouse with four parents — two mothers and two fathers — to demonstrate which parent’s genetic contribution ended up in which region of the body.
Mintz merged eight-celled embryos from two different mice, one pure black embryo and one pure white, by putting them into a lab dish, dissolving the protective layer around each embryo, and actually smooshing them together using a glass rod. The result was a mosaic mouse, with some of its cells containing genes that could be traced directly to the two white mouse parents, and some containing genes from the two black mouse parents.


After Mintz transplanted the mosaic embryo into the uterus of a foster mother, it grew to normal size, with the correct number and placement of organs. The only indication of its unnatural parental heritage, she reported, was that its coat had regularly spaced black and white stripes.
Mintz went on to create a thousand more four-parent mosaic mice mixing different traits — short-lived with long-lived, cancer-prone with cancer-resistant — so she could follow which of those cells ended up in which region of the resulting offspring. In this way, she could trace the pathway by which a developing fetus, which had begun its journey as a single mass of undifferentiated cells, was able to grow into a collection of distinctly different organs.
Other mysteries of how the embryo develops were revealed by “knockout” technology, in which scientists disabled genes in a particular region of the embryo to see what those genes controlled. In 1995, developmental biologists William Shawlot and Richard Behringer of the University of Texas MD Anderson Cancer Center in Houston reported using this method in mouse embryos, confirming Spemann’s theory that a tiny region of the embryo touches off changes in neighboring cells to turn them into particular cell types. Research that illustrates a gene’s function in embryonic development by demonstrating the damage done in its absence obviously cannot be done in human embryos, which is why it’s so helpful to have mouse models that are as targeted as these. Most of Shawlot and Behringer’s knockout mice died in utero, and the few that survived to delivery were stillborn. But the scientists had made their point: At delivery, the knockout mice lacked a forebrain and midbrain, meaning that the missing gene was a control gene that set off a reaction cascade leading to the development of the brain.
The embryo in Claudy’s uterus develops normally; everything about her pregnancy seems ordinary — except how miraculous it might feel to Claudy herself, who must have had some doubt, as a young breast cancer patient, about whether she’d ever have a baby of her own. In early July 2019, Claudy goes back to the Antoine Béclère University Hospital, this time to give birth. Her son is born on July 6; she and her partner name him Jules.
The birth showed that, even 40-plus years after the birth of the world’s first test tube baby, there were still some historic firsts to be accomplished in the field of ART: in this case, the birth of the world’s first baby born to a cancer patient from her eggs that had been matured in the laboratory and then frozen. When Grynberg asks Claudy’s permission to write up her landmark case in the Annals of Oncology, she is overwhelmed. “I thought about everything I had gone through,” she told a reporter for the British newspaper the Telegraph as she posed for a photo with baby Jules. “And I cried as I realized how lucky I was.”
— Robin Marantz Henig

Support our next century
100 years after our founding, top-quality, fiercely accurate reporting on key advances in science, technology, and medicine has never been more important – or more in need of your support. The best way to help? Subscribe.
From the archive
-
Female Sex Gland Extract Studied
Three years after estrogen was first isolated from an ovary, scientists report having purified the hormone and analyzed its chemical composition.
-
Baby Rabbits Born Normally after Fertilizing in Glass
Scientists fertilize rabbit eggs in a lab dish and implant the fertilized egg in another female rabbit.
-
Two Mothers, Two Fathers
A Science News feature story discusses the use of four-parent mice as a tool for understanding how heredity controls embryonic development.
-
Louise: Birth of a New Technology
Louise Brown is born as the world’s first “test-tube baby” through in vitro fertilization.
-
Absent Mouse Gene Leads to No-Brainer
Scientists discover that turning off a particular gene in developing mice leads to headless mice. The experiments also show that a tiny region of the embryo causes major changes to neighboring tissue.
The Latest
-
The first embryos from a mammal have now been grown in space
Mouse embryos in space can develop into clusters of cells called blastocysts. The result is a step toward understanding how human embryos will fare.
-
Human embryo replicas have gotten more complex. Here’s what you need to know
Lab-engineered human embryo models created from stem cells provide a look at development beyond the first week. But they raise ethical questions.
